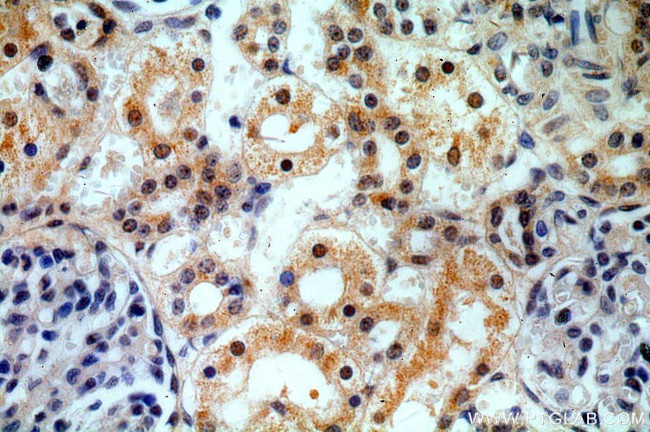
HEY1 Antibody in Immunohistochemistry (Paraffin) (IHC (P))

Search
Proteintech
HEY1 Polyclonal Antibody
{{$productOrderCtrl.translations['antibody.pdp.commerceCard.promotion.promotions']}}
{{$productOrderCtrl.translations['antibody.pdp.commerceCard.promotion.viewpromo']}}
{{$productOrderCtrl.translations['antibody.pdp.commerceCard.promotion.promocode']}}: {{promo.promoCode}} {{promo.promoTitle}} {{promo.promoDescription}}. {{$productOrderCtrl.translations['antibody.pdp.commerceCard.promotion.learnmore']}}
产品信息
19929-1-AP
种属反应
已发表种属
宿主/亚型
分类
类型
抗原
偶联物
形式
浓度
规格
纯化类型
保存液
内含物
保存条件
运输条件
产品详细信息
Immunogen sequence: VSHLNNYAS QREAASGAHA GLGHIPWGTV FGHHPHIAHP LLLPQNGHGN AGTTASPTEP HHQGRLGSAH PEAPALRAPP SGSLGPVLPV VTSASKLSPP LLSSVASLSA FPFSFGSFHL LSPNALSPSA PTQAANLGKP YR (155-295 aa encoded by BC001873)
靶标信息
Hairy/enhancer-of-split related with YRPW motif protein 1 belongs to the HEY family and is a Notch Signaling Pathway Protein. It contains one basic helix-loop-helix (bHLH) domain and one Orange domain. It is a downstream effector of Notch signaling which may be required for cardiovascular development. It acts as transcriptional repressor which binds preferentially to the canonical E box sequence 5'-CACGTG-3'. It represses transcription by the cardiac transcriptional activators GATA4 and GATA6. Hey1 is also reported to be expressed during development of the nervous system.
仅用于科研。不用于诊断过程。未经明确授权不得转售。
生物信息学
蛋白别名: basic helix loop helix factor; basic helix-loop-helix protein; basic helix-loop-helix protein OAF1; bHLHb31; Cardiovascular helix-loop-helix factor 2; CHF-2; Class B basic helix-loop-helix protein 31; Hairy and enhancer of split-related protein 1; Hairy-related transcription factor 1; Hairy/E(spl)-related with YRPW motif 1; hairy/enhancer-of-split related with YRPW motif 1; Hairy/enhancer-of-split related with YRPW motif protein 1; HES-related repressor protein 1; HES-related repressor protein 2; HESR-1; HRT-1; HRT1; MGC1274; mHRT1; transcription factor; unnamed protein product
基因别名: AI316788; AI414254; BHLHB31; CHF2; HERP2; hesr-1; HESR1; HEY1; hHRT1; HRT-1; HRT1; NERP2; OAF1
UniProt ID: (Human) Q9Y5J3
Entrez Gene ID: (Human) 23462, (Mouse) 15213, (Rat) 155437